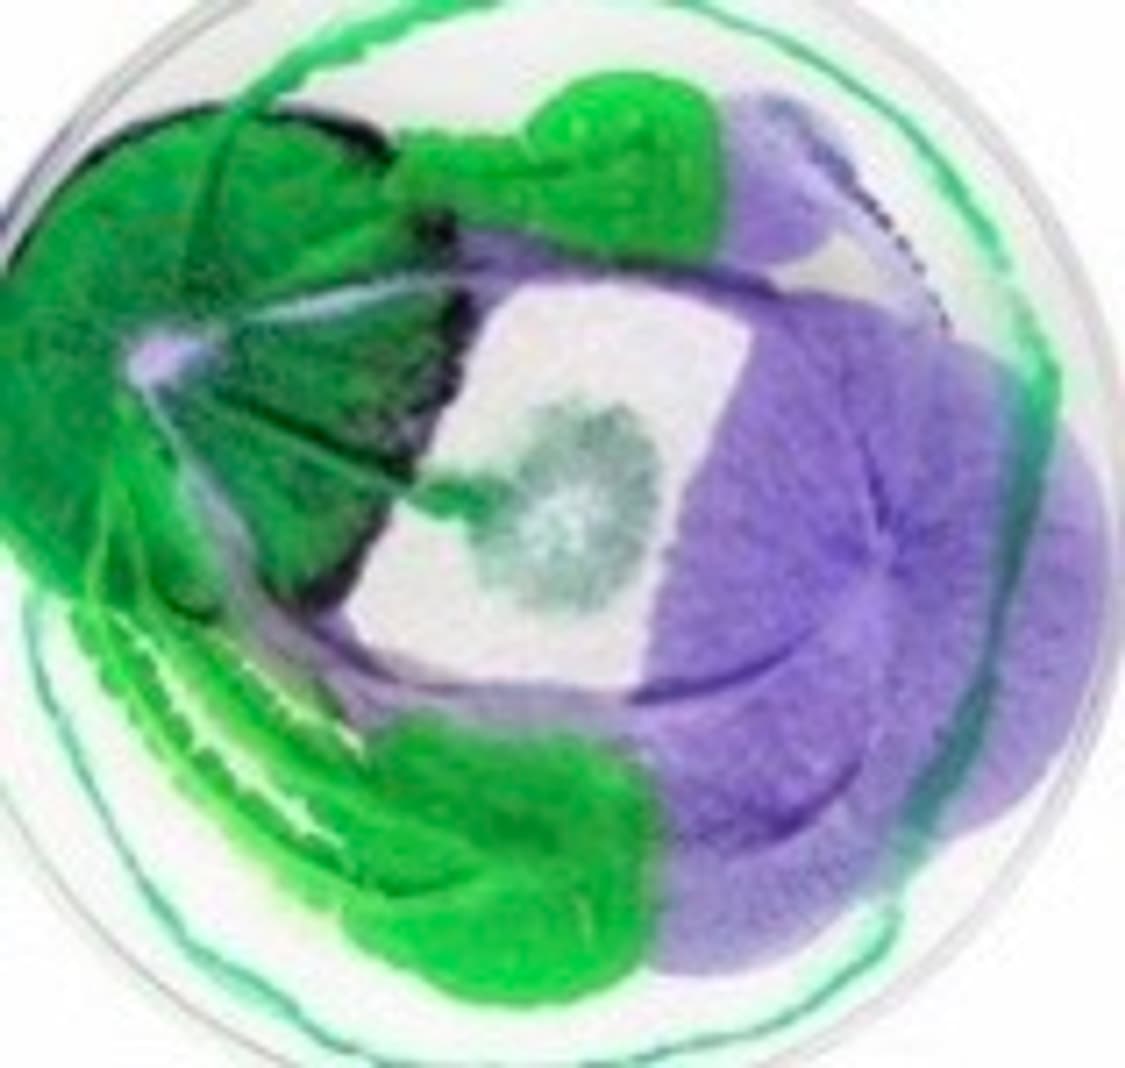
cover-image

44akii | 빈티지 세컨핸드 패션 플랫폼

44akii
@44akii
팔로워194
판매수69
평점
ig : 44aki.vintage 사사아키 빈티지입니다. 하자 및 오염은 최대한 찾아서 알려드리지만 혹여 찾지 못한 미세 불량은 환불이 어렵습니다ㅜㅜ 질문 편하게 주세요! :) 인스타 계정을 통해 구매하시면 택배비 할인혜택 받으시고, 세일제품들도 스토리를 통해 확인하실 수 있습니다 !!
ig : 44aki.vintage 사사아키 빈티지입니다. 하자 및 오염은 최대한 찾아서 알려드리지만 혹여 찾지 못한 미세 불량은 환불이 어렵습니다ㅜㅜ 질문 편하게 주세요! :) 인스타 계정을 통해 구매하시면 택배비 할인혜택 받으시고, 세일제품들도 스토리를 통해 확인하실 수 있습니다 !!